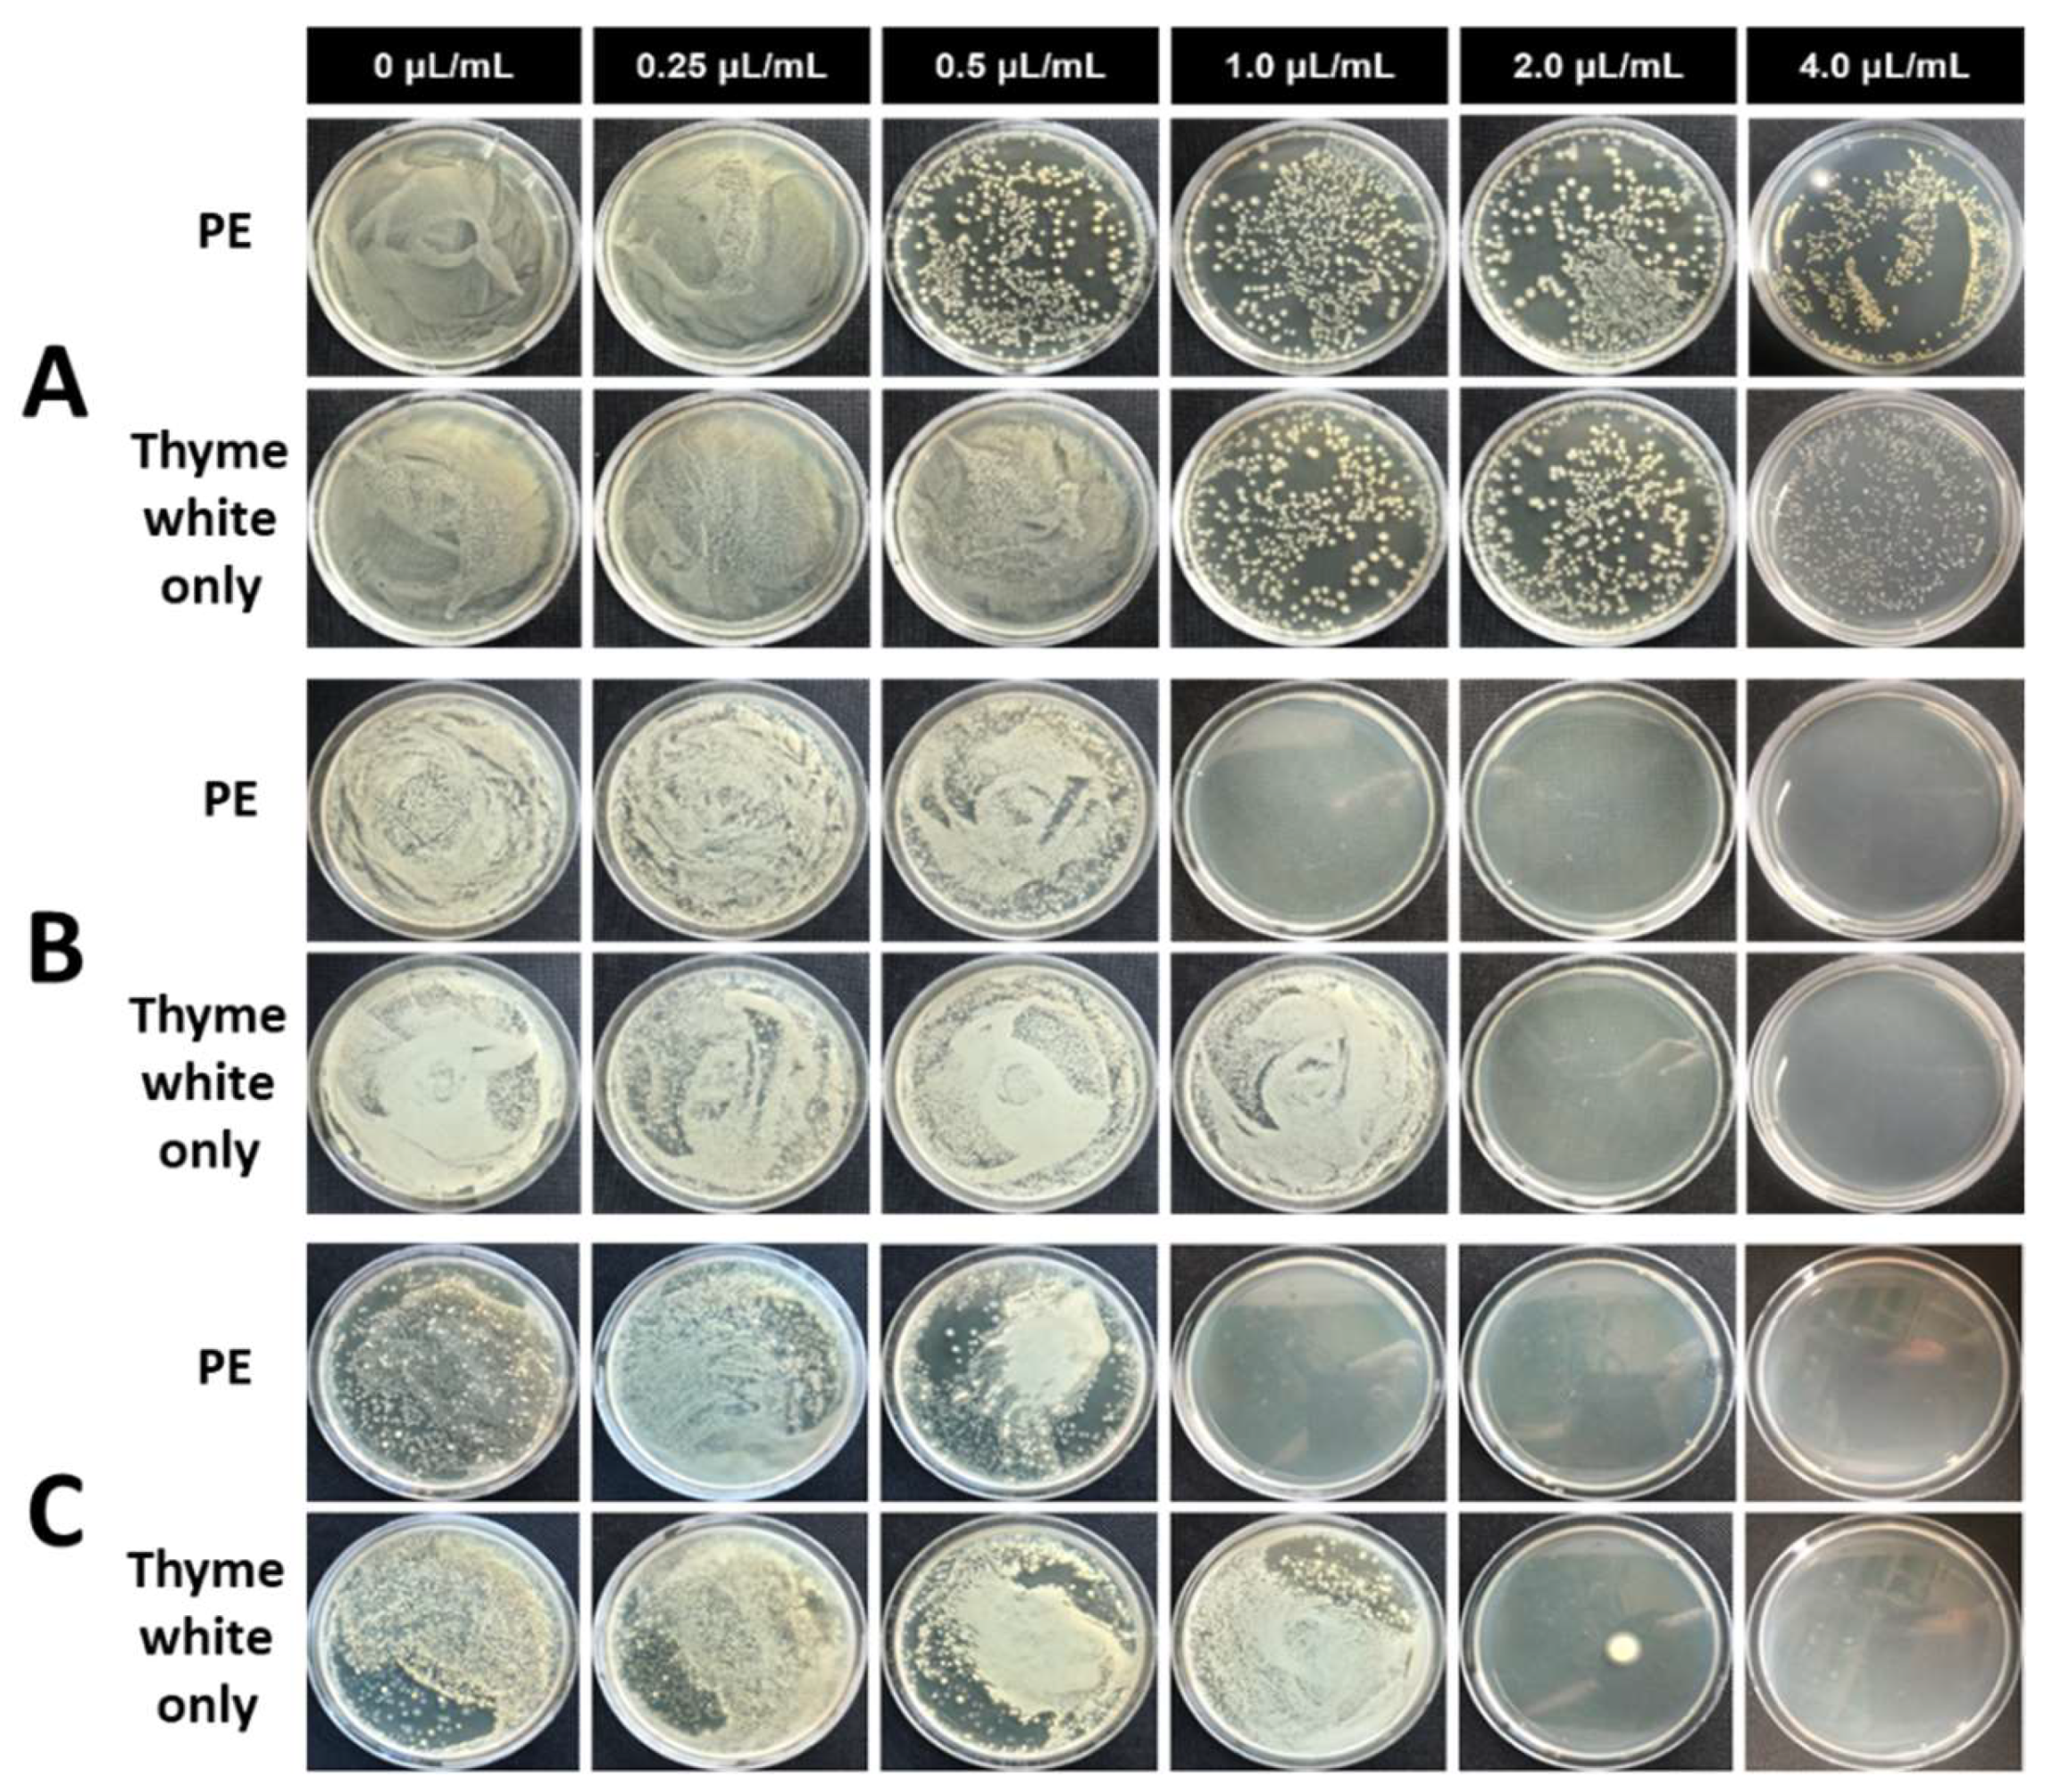
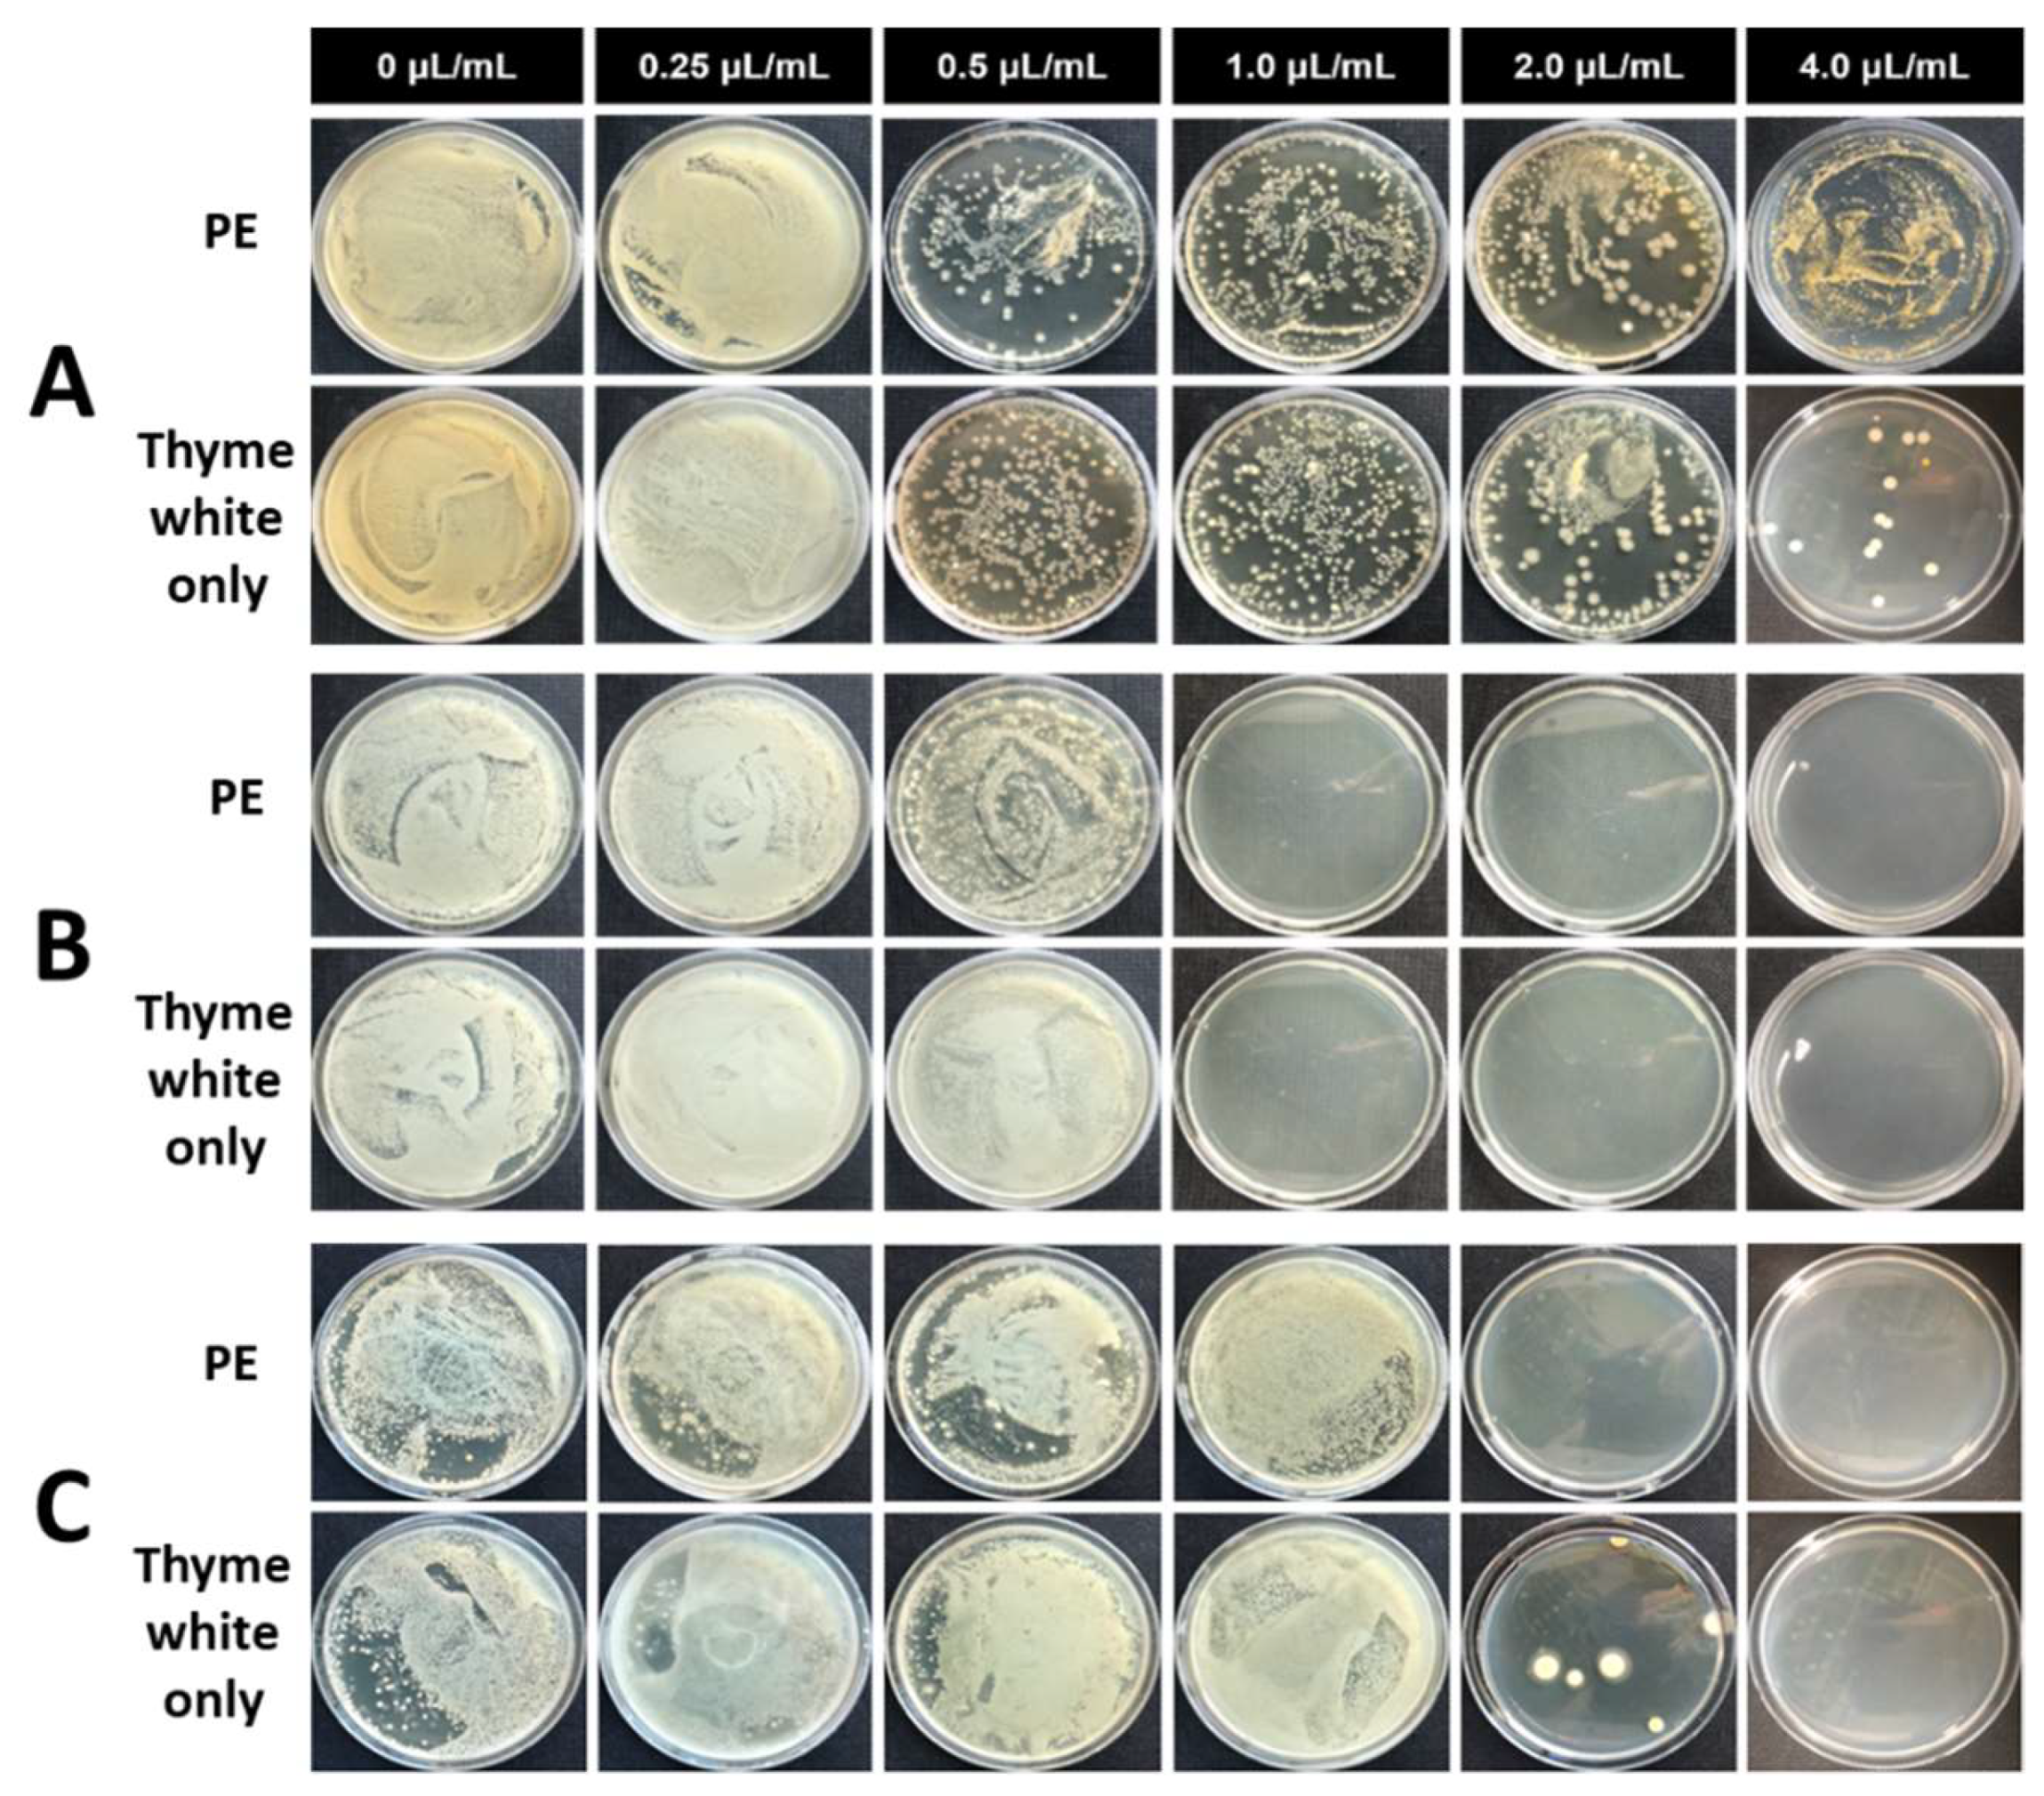

Biological Activity of Thyme White Essential Oil Stabilized by Cellulose Nanocrystals
Abstract
1. Introduction
2. Materials and Methods
2.1. Materials
2.2. Preparation and Characterization of Sulfated CNC
2.3. Preparation of CNC-Stabilized PE
2.4. Gas Chromatography (GC-FID) and Gas Chromatography–Mass Spectrometry (GC-MS)
2.5. Evaluation of Antibacterial Performance
2.6. Larvicidal Activity Test
3. Results and Discussion
4. Conclusions
Author Contributions
Funding
Conflicts of Interest
References
- Guarda, A.; Rubilar, J.F.; Miltz, J.; Galotto, M.J. The antimicrobial activity of microencapsulated thymol and carvacrol. Int. J. Food Microbiol. 2011, 146, 144–150. [Google Scholar] [CrossRef]
- Rasooli, I.; Rezaei, M.B.; Allameh, A. Ultrastructural studies on antimicrobial efficacy of thyme essential oils on Listeria monocytogenes. Int. J. Infect. Dis. 2006, 10, 236–241. [Google Scholar] [CrossRef]
- Marino, M.; Bersani, C.; Comi, G. Antimicrobial activity of the essential oils of Thymus vulgaris L. measured using a bioimpedometric method. J. Food Prot. 1999, 62, 1017–1023. [Google Scholar] [CrossRef]
- Burt, S. Essential oils: Their antibacterial properties and potential applications in foods—A review. Int. J. Food Microbiol. 2004, 94, 223–253. [Google Scholar] [CrossRef]
- Brahmi, F.; Abdenour, A.; Bruno, M.; Silvia, P.; Alessandra, P.; Danilo, F.; Drifa, Y.-G.; Fahmi, E.M.; Khodir, M.; Mohamed, C. Chemical composition and in vitro antimicrobial, insecticidal and antioxidant activities of the essential oils of Mentha pulegium L. and Mentha rotundifolia (L.) Huds growing in Algeria. Ind. Crops. Prod. 2016, 88, 96–105. [Google Scholar] [CrossRef]
- Wannes, W.A.; Mhamdi, B.; Sriti, J.; Jemia, M.B.; Ouchikh, O.; Hamdaoui, G.; Kchouk, M.E.; Marzouk, B. Antioxidant activities of the essential oils and methanol extracts from myrtle (Myrtus communis var. italica L.) leaf, stem and flower. Food Chem. Toxicol. 2010, 48, 1362–1370. [Google Scholar] [CrossRef]
- Grande-Tovar, C.D.; Chaves-Lopez, C.; Serio, A.; Rossi, C.; Paparella, A. Chitosan coatings enriched with essential oils: Effects on fungi involved in fruit decay and mechanisms of action. Trends Food Sci. Technol. 2018, 78, 61–71. [Google Scholar] [CrossRef]
- Peng, Y.; Li, Y. Combined effects of two kinds of essential oils on physical, mechanical and structural properties of chitosan films. Food Hydrocoll. 2014, 36, 287–293. [Google Scholar] [CrossRef]
- Bonizzoni, M.; Gasperi, G.; Chen, X.; James, A.A. The invasive mosquito species Aedes albopictus: Current knowledge and future perspectives. Trends Parasitol. 2013, 29, 460–468. [Google Scholar] [CrossRef]
- World Health Organization. Global Insecticide Use for Vector-Borne Disease Control: A 10-Year Assessment 2000–2009, 5th ed.; World Health Organization: Geneva, Switzerland, 2011. [Google Scholar]
- Vontas, J.; Kioulos, E.; Pavlidi, N.; Morou, E.; Della Torre, A.; Ranson, H. Insecticide resistance in the major dengue vectors Aedes albopictus and Aedes aegypti. Pestic. Biochem. Physiol. 2012, 104, 126–131. [Google Scholar] [CrossRef]
- Anadu, D.; Anaso, H.; Onyeka, O. Acute toxicity of the insect larvicide abate® (temephos) on the fish Tilapia melanopleura and the dragonfly larvae Neurocordelia virginiensis. J. Environ. Sci. Health B 1996, 31, 1363–1375. [Google Scholar] [CrossRef]
- Abban, E.; Samman, J. Preliminary observations on the effect of the insect larvicide abate on fish catches in the river Oti, Ghana. Environ. Pollut. Ser. A Ecol. Biol. 1980, 21, 307–311. [Google Scholar] [CrossRef]
- Jantan, I.b.; Yalvema, M.F.; Ahmad, N.W.; Jamal, J.A. Insecticidal activities of the leaf oils of eight Cinnamomum. species against Aedes aegypti. and Aedes albopictus. Pharm. Biol. 2005, 43, 526–532. [Google Scholar]
- Cheng, S.S.; Chang, H.T.; Lin, C.Y.; Chen, P.S.; Huang, C.G.; Chen, W.J.; Chang, S.T. Insecticidal activities of leaf and twig essential oils from Clausena excavata against Aedes aegypti and Aedes albopictus larvae. Pest Manag. Sci.: Formerly Pesticide Sci. 2009, 65, 339–343. [Google Scholar] [CrossRef]
- Benelli, G.; Flamini, G.; Fiore, G.; Cioni, P.L.; Conti, B. Larvicidal and repellent activity of the essential oil of Coriandrum sativum L.(Apiaceae) fruits against the filariasis vector Aedes albopictus Skuse (Diptera: Culicidae). Parasitol. Res. 2013, 112, 1155–1161. [Google Scholar] [CrossRef]
- Conti, B.; Benelli, G.; Flamini, G.; Cioni, P.L.; Profeti, R.; Ceccarini, L.; Macchia, M.; Canale, A. Larvicidal and repellent activity of Hyptis suaveolens (Lamiaceae) essential oil against the mosquito Aedes albopictus Skuse (Diptera: Culicidae). Parasitol. Res. 2012, 110, 2013–2021. [Google Scholar] [CrossRef]
- Govindarajan, M.; Sivakumar, R.; Rajeswary, M.; Yogalakshmi, K. Chemical composition and larvicidal activity of essential oil from Ocimum basilicum (L.) against Culex tritaeniorhynchus, Aedes albopictus and Anopheles subpictus (Diptera: Culicidae). Exp. Parasitol. 2013, 134, 7–11. [Google Scholar] [CrossRef]
- Osanloo, M.; Amani, A.; Sereshti, H.; Abai, M.R.; Esmaeili, F.; Sedaghat, M.M. Preparation and optimization nanoemulsion of Tarragon (Artemisia dracunculus) essential oil as effective herbal larvicide against Anopheles stephensi. Ind. Crops Prod. 2017, 109, 214–219. [Google Scholar] [CrossRef]
- Pickering, S.U. Cxcvi.—Emulsions. J. Chem. Soc. Trans. 1907, 91, 2001–2021. [Google Scholar] [CrossRef]
- Ramsden, W. Separation of solids in the surface-layers of solutions and ‘suspensions’ (observations on surface-membranes, bubbles, emulsions, and mechanical coagulation).—Preliminary account. Proc. R. Soc. Lond. 1904, 72, 156–164. [Google Scholar]
- Torres, L.G.; Iturbe, R.; Snowden, M.J.; Chowdhry, B.Z.; Leharne, S.A. Preparation of o/w emulsions stabilized by solid particles and their characterization by oscillatory rheology. Colloid Surf. A 2007, 302, 439–448. [Google Scholar] [CrossRef]
- Kalashnikova, I.; Bizot, H.; Cathala, B.; Capron, I. Modulation of cellulose nanocrystals amphiphilic properties to stabilize oil/water interface. Biomacromolecules 2012, 13, 267–275. [Google Scholar] [CrossRef]
- Wei, Y.P.; Cheng, F.; Hou, G.; Sun, S.F. Amphiphilic cellulose: Surface activity and aqueous self-assembly into nano-sized polymeric micelles. React. Funct. Polym. 2008, 68, 981–989. [Google Scholar] [CrossRef]
- Kalashnikova, I.; Bizot, H.; Cathala, B.; Capron, I. New Pickering emulsions stabilized by bacterial cellulose nanocrystals. Langmuir 2011, 27, 7471–7479. [Google Scholar] [CrossRef]
- Cunha, A.G.; Mougel, J.B.; Cathala, B.; Berglund, L.A.; Capron, I. Preparation of double Pickering emulsions stabilized by chemically tailored nanocelluloses. Langmuir 2014, 30, 9327–9335. [Google Scholar] [CrossRef]
- Bai, L.; Huan, S.Q.; Xiang, W.C.; Rojas, O.J. Pickering emulsions by combining cellulose nanofibrils and nanocrystals: Phase behavior and depletion stabilization. Green Chem. 2018, 20, 1571–1582. [Google Scholar] [CrossRef]
- Jiménez Saelices, C.; Capron, I. Design of Pickering micro-and nanoemulsions based on the structural characteristics of nanocelluloses. Biomacromolecules 2018, 19, 460–469. [Google Scholar] [CrossRef]
- Kalashnikova, I.; Bizot, H.; Bertoncini, P.; Cathala, B.; Capron, I. Cellulosic nanorods of various aspect ratios for oil in water Pickering emulsions. Soft Matter 2013, 9, 952–959. [Google Scholar] [CrossRef]
- Saidane, D.; Perrin, E.; Cherhal, F.; Guellec, F.; Capron, I. Some modification of cellulose nanocrystals for functional Pickering emulsions. Philos. Trans. A Math. Phys. Eng. Sci. 2016, 374, 20150139. [Google Scholar] [CrossRef]
- Jimenez-Saelices, C.; Seantier, B.; Grohens, Y.; Capron, I. Thermal Superinsulating Materials Made from Nanofibrillated Cellulose-Stabilized Pickering Emulsions. ACS Appl. Mater. Inter. 2018, 10, 16193–16202. [Google Scholar] [CrossRef]
- Bai, L.; Greca, L.G.; Xiang, W.; Lehtonen, J.; Huan, S.; Nugroho, R.W.N.; Tardy, B.L.; Rojas, O.J. Adsorption and assembly of cellulosic and lignin colloids at oil/water interfaces. Langmuir 2018, 35, 571–588. [Google Scholar] [CrossRef] [PubMed]
- Habibi, M.H.; Sheibani, R. Removal of 2-mercaptobenzoxazole from water as model of odorous mercaptan compounds by a heterogenous photocatalytic process using Ag-ZnO nanocomposite coated thin film on glass plate. Bull. Environ. Contam. Toxicol. 2010, 85, 589–592. [Google Scholar] [CrossRef]
- Roman, M.; Winter, W.T. Effect of sulfate groups from sulfuric acid hydrolysis on the thermal degradation behavior of bacterial cellulose. Biomacromolecules 2004, 5, 1671–1677. [Google Scholar] [CrossRef]
- Lu, P.; Hsieh, Y.-L. Preparation and properties of cellulose nanocrystals: Rods, spheres, and network. Carbohydr. Polym. 2010, 82, 329–336. [Google Scholar] [CrossRef]
- Kwon, O.; Shin, S.-J. Electron microscopy for the morphological characterization of nanocellulose materials. J. Korea Tech. Assoc. Pulp. Pap. Ind. 2016, 48, 5–18. [Google Scholar] [CrossRef]
- da Silva Perez, D.; Montanari, S.; Vignon, M.R. TEMPO-mediated oxidation of cellulose III. Biomacromolecules 2003, 4, 1417–1425. [Google Scholar] [CrossRef]
- Tang, Z.; Li, W.; Lin, X.; Xiao, H.; Miao, Q.; Huang, L.; Chen, L.; Wu, H. TEMPO-oxidized cellulose with high degree of oxidation. Polymers 2017, 9, 421. [Google Scholar] [CrossRef]
- Shin, S.; Hyun, J. Matrix-assisted three-dimensional printing of cellulose nanofibers for paper microfluidics. ACS Appl. Mater. Inter. 2017, 9, 26438–26446. [Google Scholar] [CrossRef]
- Wiegand, I.; Hilpert, K.; Hancock, R.E.W. Agar and broth dilution methods to determine the minimal inhibitory concentration (MIC) of antimicrobial substances. Nat. Protoc. 2008, 3, 163–175. [Google Scholar] [CrossRef]
- Moraes-Lovison, M.; Marostegan, L.F.; Peres, M.S.; Menezes, I.F.; Ghiraldi, M.; Rodrigues, R.A.; Fernandes, A.M.; Pinho, S.C. Nanoemulsions encapsulating oregano essential oil: Production, stability, antibacterial activity and incorporation in chicken pâté. LWT 2017, 77, 233–240. [Google Scholar] [CrossRef]
- Wang, J.; Li, X.; Chen, M.; Chen, Z.; Wu, H.; Zhang, P.; Yuan, T.; Yang, Z.; Hu, Y. Fabrication of sustained-release and antibacterial citronella oil-loaded composite microcapsules based on Pickering emulsion templates. J. Appl. Polym. Sci. 2018, 135, 46386. [Google Scholar] [CrossRef]
- Kim, J.-E.; Lee, J.-E.; Huh, M.-J.; Lee, S.-C.; Seo, S.-M.; Kwon, J.H.; Park, I.-K. Fumigant antifungal activity via reactive oxygen species of Thymus vulgaris and Satureja hortensis essential oils and constituents against Raffaelea quercus-mongolicae and Rhizoctonia solani. Biomolecules 2019, 9, 561. [Google Scholar] [CrossRef]
- Zambonelli, A.; D’Aulerio, A.Z.; Severi, A.; Benvenuti, S.; Maggi, L.; Bianchi, A. Chemical composition and fungicidal activity of commercial essential oils of Thymus vulgaris L. J. Essent. Oil Res. 2004, 16, 69–74. [Google Scholar] [CrossRef]
- Zhang, H.; Qian, Y.; Chen, S.; Zhao, Y. Physicochemical characteristics and emulsification properties of cellulose nanocrystals stabilized O/W pickering emulsions with high-OSO3-groups. Food Hydrocoll. 2019, 96, 267–277. [Google Scholar] [CrossRef]
- Cherhal, F.; Cousin, F.; Capron, I. Structural description of the interface of Pickering emulsions stabilized by cellulose nanocrystals. Biomacromolecules 2016, 17, 496–502. [Google Scholar] [CrossRef] [PubMed]
- Tang, C.; Chen, Y.; Luo, J.; Low, M.Y.; Shi, Z.; Tang, J.; Zhang, Z.; Peng, B.; Tam, K.C. Pickering emulsions stabilized by hydrophobically modified nanocellulose containing various structural characteristics. Cellulose 2019, 26, 7753–7767. [Google Scholar] [CrossRef]
- Ziaee, E.; Razmjooei, M.; Shad, E.; Eskandari, M.H. Antibacterial mechanisms of Zataria multiflora Boiss. essential oil against Lactobacillus curvatus. LWT Food Sci. Technol. 2018, 87, 406–412. [Google Scholar] [CrossRef]
- Zhou, Y.; Sun, S.; Bei, W.; Zahi, M.R.; Yuan, Q.; Liang, H. Preparation and antimicrobial activity of oregano essential oil Pickering emulsion stabilized by cellulose nanocrystals. Int. J. Biol. Macromol. 2018, 112, 7–13. [Google Scholar] [CrossRef]
- Seo, S.-M.; Jung, C.-S.; Kang, J.; Lee, H.-R.; Kim, S.-W.; Hyun, J.; Park, I.-K. Larvicidal and acetylcholinesterase inhibitory activities of Apiaceae plant essential oils and their constituents against Aedes albopictus and formulation development. J. Agric. Food Chem. 2015, 63, 9977–9986. [Google Scholar] [CrossRef]

| Compounds | Retention Indices | Composition Rate (%) | |
|---|---|---|---|
| DB-1MS | HP-Innowax | ||
| α-Pinene | 928 | 1021 | 7.22 |
| Camphene | 940 | 1064 | 1.32 |
| β-Pinene | 967 | 1108 | 0.66 |
| β-Myrcene | 982 | 1165 | 0.96 |
| α-Phellandrene | 994 | 1165 | 0.16 |
| p-Cymene | 1010 | 1275 | 38.14 |
| Limonene | 1020 | 1200 | 7.93 |
| γ-Terpinene | 1050 | 1248 | 0.38 |
| Linalool | 1088 | 1538 | 3.57 |
| α-Terpineol | 1170 | 1707 | 0.25 |
| Thymol | 1273 | 2207 | 35.82 |
| Carvacrol | 1278 | 2235 | 0.45 |
| Sum | - | - | 93.29 |
| Dilution of Antimicrobial Compounds for Same No. of Bacteria (μL/mL) | Antimicrobial Activity (MIC, Escherichia coli) | |||||||
|---|---|---|---|---|---|---|---|---|
| 0.125 2 | 0.150 | 0.250 | 0.312 | 0.500 | 0.625 | 1.000 | 1.250 | |
| Thyme White Only | + | + | + | + | + | - | - | - |
| CNC/EO PEs | + | + | + | - | - | - | - | - |
| Streptomycin | - | - | - | - | - | - | - | - |
| Dilution of Antimicrobial Compounds for Same No. of Bacteria (μL/mL) | Antimicrobial Activity (MIC, Staphylococcus aureus) | |||||||
|---|---|---|---|---|---|---|---|---|
| 0.125 2 | 0.150 | 0.250 | 0.312 | 0.500 | 0.625 | 1.000 | 1.250 | |
| Thyme White Only | + | + | + | + | + | - | - | - |
| CNC/EO PEs | + | + | - | - | - | - | - | - |
| Streptomycin | - | - | - | - | - | - | - | - |
| Dilution of Antimicrobial Compounds for Same No. of Bacteria (μL/mL) | Antimicrobial Activity (MBC, Escherichia coli) | ||||||||
|---|---|---|---|---|---|---|---|---|---|
| 0.600 2 | 0.650 | 0.700 | 0.750 | 0.800 | 0.850 | 0.900 | 0.950 | 1.000 | |
| Thyme White Only | + | + | + | + | + | + | + | + | - |
| CNC/EO PEs | + | + | + | - | - | - | - | - | - |
| Streptomycin | - | - | - | - | - | - | - | - | - |
| Dilution of Antimicrobial Compounds for Same No. of Bacteria (μL/mL) | Antimicrobial Activity (MBC, Staphylococcus aureus) | ||||||||
|---|---|---|---|---|---|---|---|---|---|
| 0.600 2 | 0.650 | 0.700 | 0.750 | 0.800 | 0.850 | 0.900 | 0.950 | 1.000 | |
| Thyme White Only | + | + | + | + | + | + | + | + | - |
| CNC/EO PEs | + | - | - | - | - | - | - | - | - |
| Streptomycin | - | - | - | - | - | - | - | - | - |
| Compounds | Larvicidal Activity (%, Mean ± S.E, N = 4) | ||
|---|---|---|---|
| 0.1 1 | 0.05 | 0.025 | |
| Thyme White Only | 100 | 0 | - 2 |
| CNC/EO PEs | 100 | 100 | 38.0 ± 8.0 |
| Ethanol Only | 0 | 0 | 0 |
| CNC Only | 0 | 0 | 0 |
| Temephos | 100 | 100 | 100 |
© 2019 by the authors. Licensee MDPI, Basel, Switzerland. This article is an open access article distributed under the terms and conditions of the Creative Commons Attribution (CC BY) license (http://creativecommons.org/licenses/by/4.0/).
Share and Cite
Shin, J.; Na, K.; Shin, S.; Seo, S.-M.; Youn, H.J.; Park, I.-K.; Hyun, J. Biological Activity of Thyme White Essential Oil Stabilized by Cellulose Nanocrystals. Biomolecules 2019, 9, 799. https://doi.org/10.3390/biom9120799
Shin J, Na K, Shin S, Seo S-M, Youn HJ, Park I-K, Hyun J. Biological Activity of Thyme White Essential Oil Stabilized by Cellulose Nanocrystals. Biomolecules. 2019; 9(12):799. https://doi.org/10.3390/biom9120799
Chicago/Turabian StyleShin, Jonghyun, Kyunga Na, Sungchul Shin, Seon-Mi Seo, Hye Jung Youn, Il-Kwon Park, and Jinho Hyun. 2019. "Biological Activity of Thyme White Essential Oil Stabilized by Cellulose Nanocrystals" Biomolecules 9, no. 12: 799. https://doi.org/10.3390/biom9120799
APA StyleShin, J., Na, K., Shin, S., Seo, S.-M., Youn, H. J., Park, I.-K., & Hyun, J. (2019). Biological Activity of Thyme White Essential Oil Stabilized by Cellulose Nanocrystals. Biomolecules, 9(12), 799. https://doi.org/10.3390/biom9120799

